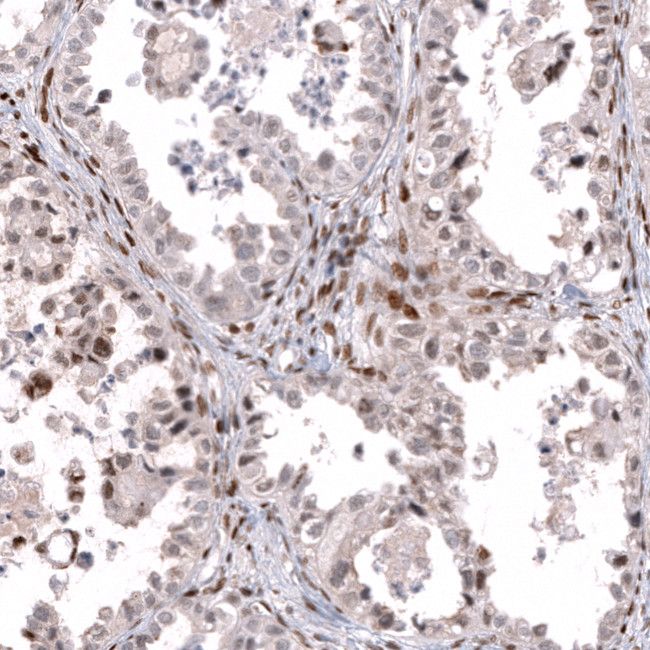
TFE3 Antibody in Immunohistochemistry (Paraffin) (IHC (P))

Search
Invitrogen
TFE3 Monoclonal Antibody (CL12810)
{{$productOrderCtrl.translations['antibody.pdp.commerceCard.promotion.promotions']}}
{{$productOrderCtrl.translations['antibody.pdp.commerceCard.promotion.viewpromo']}}
{{$productOrderCtrl.translations['antibody.pdp.commerceCard.promotion.promocode']}}: {{promo.promoCode}} {{promo.promoTitle}} {{promo.promoDescription}}. {{$productOrderCtrl.translations['antibody.pdp.commerceCard.promotion.learnmore']}}
产品信息
MA5-46523
种属反应
宿主/亚型
分类
类型
克隆号
抗原
偶联物
形式
浓度
规格
纯化类型
保存液
内含物
保存条件
运输条件
RRID
产品详细信息
Highest antigen sequence indentity to the following orthologs: Mouse - 93%, Rat - 92%.
靶标信息
The activation of gene transcription is a multistep process that is triggered by factors that recognize transcriptional enhancer sites in DNA. These factors work with co-activators to direct transcriptional initiation by the RNA polymerase II apparatus. The protein encoded by this gene is a subunit of the CRSP (cofactor required for SP1 activation) complex, which, along with TFIID, is required for efficient activation by SP1. This protein is also a component of other multisubunit complexes e.g. thyroid hormone receptor-(TR-) associated proteins which interact with TR and facilitate TR function on DNA templates in conjunction with initiation factors and cofactors. This protein contains a bipartite nuclear localization signal. This gene is known to escape chromosome X-inactivation.
仅用于科研。不用于诊断过程。未经明确授权不得转售。
篇参考文献 (0)
生物信息学
蛋白别名: bHLHe33; Class E basic helix-loop-helix protein 33; transcription factor E family, member A; Transcription factor E3; transcription factor for IgH enhancer; transcription factor for immunoglobulin heavy-chain enhancer 3; unnamed protein product
基因别名: BHLHE33; MRXSPF; RCCP2; RCCX1; TFE3; TFEA
UniProt ID: (Human) P19532
Entrez Gene ID: (Human) 7030